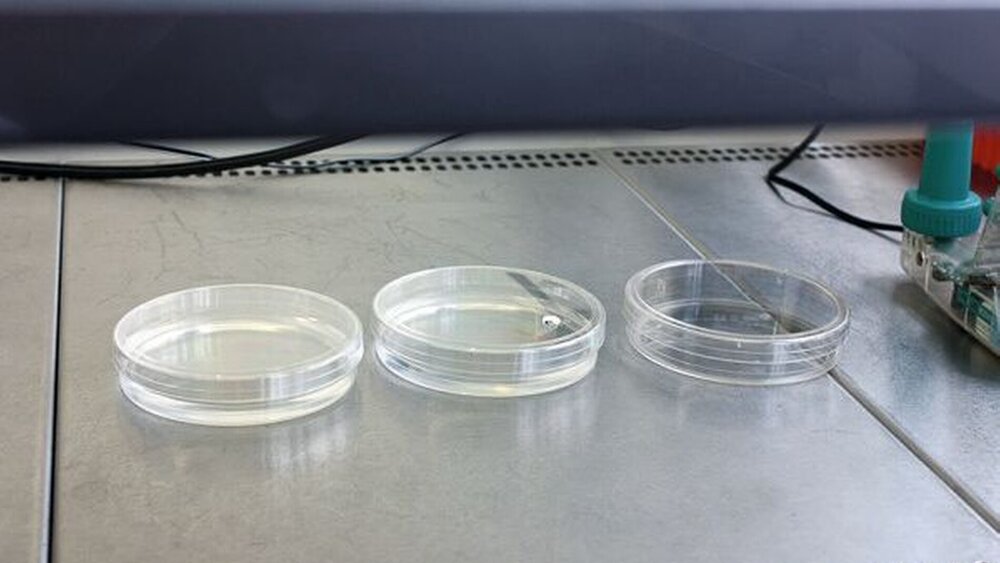

Zukunft Zahnbank
Unter Kryopräservation versteht man die Methode, lebende Zellen mittels kontrollierter Tiefkühlung zu konservieren. Die Lagerung in gasförmigem Stickstoff bringt den Stoffwechsel der Zellen praktisch zum Stillstand. So ist es mithilfe der Kryopräservation möglich, kariesfreie und parodontal gesunde Zähne, die beispielsweise aus kieferorthopädischen Gründen entfernt werden, aufzubewahren und zu einem späteren Zeitpunkt bei einem Zahnverlust als autologes Transplantat zu verwenden.
Insbesondere bei Kindern und Jugendlichen können verlorene Zähne auf diese Weise biologisch und kostengünstig ersetzt werden. Implantate sind aufgrund des nicht abgeschlossenen Kieferwachstums bei Patienten in dieser Altersgruppe nicht indiziert. An den Universitätskliniken für Zahnmedizin der Universität Basel werden derzeit erste Erfahrungen gesammelt und Schritte in Richtung Aufbau einer Zahnbank getan.
Die Transplantation von Zähnen hat in der Zahnmedizin ihren festen Stellenwert. Sie kann bei Kindern und Jugendlichen einen nicht erhaltungswürdigen Zahn (Karies), einen verloren gegangenen Zahn (Zahntrauma) oder einen nicht angelegten Zahn durch einen eigenen ersetzen. Die Zahntransplantation ist in dieser Altersgruppe vielfach anderen Arten des Zahnersatzes, wie beispielsweise kieferorthopädischem Lückenschluss oder Klebebrücken, hinsichtlich Behandlungsdauer, Ästhetik und Funktion überlegen.
Autologe Zahntransplantationen werden heute mit hohen Erfolgsraten und gutem Langzeiterfolg durchgeführt [Andreasen 1992, Andreasen et al. 1970, Galanter & Minami 1968, Hovinga 1986, Singh & Dudani 1970, Thrheyden et al. 1995, Frenken et al. 1998, Slagsvold & Bjercke 1978, Stöckli 1994, Pohl et al. 2005, Lang et al. 2003]. Zur Zahntransplantation eignen sich besonders Weisheitszähne, Prämolaren und Milcheckzähne [Lang et al. 2003, Filippi 2009]. Allerdings stellt sich häufiger das Problem der Verfügbarkeit autologer Transplantate, denn Zähne gehen in den seltensten Fällen vor oder genau zu dem Zeitpunkt verloren, zu dem potentielle Transplantate entfernt werden und zur Verfügung stehen würden. Im Zuge kieferorthopädischer Behandlungen müssen nicht selten parodontal gesunde, kariesfreie und pulpavitale Prämolaren aus Platzgründen entfernt werden. Gerade diese fast perfekten Transplantate gehen ohne Nutzen verloren. Es ist daher zu überlegen, ob diese Zähne nicht aufbewahrt werden sollten, um später allenfalls beim selben Patienten an einer anderen Stelle transplantiert zu werden.
Kryopräservation ist eine Methode, vitale Zellen und Gewebe in flüssigem Stickstoff bei -196°C über lange Zeiträume hinweg zu konservieren. Diese überprüfte Technik ist aus anderen Bereichen der Medizin (beispielsweise Nabelschnurblut) und der Biologie bekannt. Der Stoffwechsel der Zellen und somit auch die Zellalterung kommen bei diesen Temperaturen praktisch zum Stillstand, ohne dass die Überlebensfähigkeit relevant beeinträchtigt würde. Untersuchungen nach dem Auftauen von kryopräservierten Zähnen haben beispielsweise gezeigt, dass etwa 97 Prozent der Zellen auf der Wurzeloberfläche vital und proliferationsfähig bleiben [Oh et al. 2005].
Es konnte in der Zellkultur bewiesen werden, dass Parodontalzellen auf Wurzeloberflächen bereits nach wenigen Tagen sich wieder zu teilen beginnen. Sie bilden ein intaktes, vom normalen Zahnhalteapparat nicht zu unterscheidendes Parodont [Andreasen 1992, Andreasen 1983] (Abbildung 2). Auch bei der Revaskularisation der Pulpa gibt es keine signifikanten Unterschiede zwischen sofort transplantierten Zähnen und zuvor kryopräservierten Zähnen [Price 1972, Laureys et al. 2001].
Kritisch ist nicht der Lagerungszeitraum, sondern der Einfrier- und Auftauvorgang sowie allfällige Temperaturschwankungen während der Lagerungszeit (Abbildungen 6 und 7). Während der Kryopräservation kann es im Parodont zu intrazellulärer Eiskristallbildung und damit zu Zellschäden kommen, weshalb dem kryopräservativen Zusatz (Kristallisationsschutzmittel) in den speziell verwendeten Containern große Bedeutung zukommt. Dieses Kristallisationsschutzmittel reduziert die intrazelluläre Eiskristallbildung während des Gefriervorgangs [Leibo 1981]. Bei optimalen Bedingungen sind daher Lagerungszeiten von Zähnen in einem Zahnbanktank von mehreren Jahren ohne wesentlichen Qualitätsverlust möglich [Andreasen 1992, Oh et al. 2005].
Indikationen zur Kryopräservation
Neben Prämolaren, die aus kieferorthopädischen Gründen entfernt werden, stellen avulsierte Zähne (meist obere Schneidezähne) eine weitere Indikation für die Kryopräservation dar. Manchmal können avulsierte Zähne weder am Unfalltag noch an den darauf folgenden Tagen replantiert werden, weil entweder schwere allgemeinmedizinische Verletzungen, die Behandlungspriorität besitzen, oder erhebliche lokale Weichgewebsverluste bestehen, die zuerst reepithelisieren müssen, bevor eine Replantation überhaupt möglich ist [Kristerson et al. 1976]. Eine weitere Indikation zur Kryopräservation sind Kieferfrakturen mit Zähnen im Bruchspalt. Diese müssen häufig vor Osteosynthese entfernt werden [Hillerup 1987]. Auch bei Patienten mit Dysostosis cleidocranialis könnten überzählige retinierte Zähne kryopräserviert und für den späteren Gebrauch konserviert werden.
Voraussetzungen zur Kryopräservation
Für jede Kryopräservation mit Blutbestandteilen gereinigtTrans- beziehungsweise Replantation ist erforderlich, dass die Zähne so gewebeschonend wie möglich entfernt worden sind, was insbesondere bei einer Avulsion nicht immer gewährleistet ist.
Die Wurzeln von Prämolaren sollten etwa zu 50 bis 75 Prozent ausgebildet sein, um das Überleben der Pulpa vorhersagbar zu ermöglichen [Henrichvark et al. 1987].
Vor einer möglichen Kryopräservation müssen alle Patienten oder deren Erziehungsberechtigte mündlich und schriftlich ausführlich über das Verfahren und den Umgang mit ihren Zähnen aufgeklärt werden.
Technik dieser Behandlungsmethode
Gewebe- und zellschonendes operatives Vorgehen
Die zervikalen gingivalen Fasern werden grundsätzlich vor Zahnentfernung mit einem schmalen Skalpell durchtrennt, um diese Strukturen weitgehend zu erhalten (Schnittwunde versus Rissquetschwunde). Die Zahnentfernung (Transplantatentnahme) erfolgt ohne Hebel oder kippende Zangenbewegungen, weil beides zum großflächigen parodontalen Zelltod führen kann. Der Zahn wird unter leichten Rotationsbewegungen oder durch Zahnlängsextraktion (Zalex) [Pohl 2008] entfernt. Die Wurzeloberfläche darf weder mit der Zange noch mit anderen Instrumenten tangiert werden; Zement- und Zementoblastend efekte erhöhen das Risiko von Wurzel -resorptionen und reduzieren die Chance einer funktionellen parodontalen Heilung (functional healing). Für eine mögliche Kryopräservation werden vor allem einwurzlige Zähne (Frontzähne, Eckzähne und Prämolaren) aufgrund ihrer einfacheren Wurzelanatomie (falls spätere Wurzelkanalbehandlung erforderlich) und ihres Platzbedarfs im Container favorisiert.
Zellphysiologischer Transport ins Labor
Der Zahn wird unmittelbar nach der Entfernung in ein zellphysiologisches Lagerungsmedium gebracht (Dentosafe, (Fa. Medice Arzneimittel Pütter, Iserlohn, D, oder SOS Zahnbox, (Fa. Hager& Werken, Duisburg, D, oder Curasafe, (Healthco-Breitschmid AG, Kriens, CH) [Eskici 2003, Filippi 2009]. In einer solchen Box kann der Zahn ohne Eile in ein für Kryopräservation zertifiziertes Labor oder Institut gebracht werden. Das Überleben der Zellen auf der Wurzeloberfläche des Zahnes (Parodontalfibroblasten, Zementoblasten) ist für mindestens 24 Stunden gewährleistet.
Zellphysiologisches Einfrieren des Zahnes
Der Zahn wird zunächst in mehreren mit PBS (Phosphate buffered saline, pH 7,2) gefüllten Petrischalen von anhaftenden Proteinen und Blutbestandteilen gereinigt (Abbildung 3).
Der Zahn kommt dann in ein optimiertes Zellnährmedium (wie RPMI, Ross-Park-Memorial-Institute-Medium), dem fetales Kälberserum (FCS, 40 Prozent) und ein kryoprotektiver Zusatz (zehn Prozent DMSO, Dimethylsulfoxid) zugegeben ist. In einem für das Einfrieren geeigneten verschraubbaren Container (Fa. Nunc, Inhalt 1,8ml) wird der Zahn platziert (Abbildung 4).
Der verschlossene Container wird in einen mit Isopropanol gefüllten Behälter eingebracht, damit ein langsames Abkühlen garantiert ist (Abbildung 5). Dieser Behälter wird über Nacht in einem Gefrierschrank gelagert und auf -70° Celsius heruntergekühlt. Am folgenden Tag wird der Container in speziellen Racks platziert, welche in gasförmigem Stickstoff (-196° Celsius) für beliebig lange gelagert werden (Abbildung 6) [Schwartz 1986].
Zellphysiologisches Auftauen des Zahnes
Der Container wird dem gasförmigen Stickstoff (-196°C) entnommen. Das Auftauen geschieht in einem 37°C warmen Wasserbad unter schwenkenden Bewegungen. Sobald das den Zahn umgebende Gemisch aus Zellkulturmedium und Kristallisationsschutzmittel beginnt flüssig zu werden, wird der Zahn dem Container entnommen und in Petrischalen mit PBS im Sinne einer Verdünnungsreihe gereinigt (Abbildung 7). Der Zahn wird anschließend sofort in einer Zahnrettungsbox bis zur sich anschließenden Trans- oder Replantation gelagert [Schwartz 1986].
Transplantation des Zahnes
Das chirurgische Vorgehen nach Kryopräservation und Auftauen entspricht weitgehend dem einer sofortigen Transplantation eines Zahnes [Filippi 2009].
Das Transplantatbett (Knochen und Weichgewebe) muss jedoch aufgrund des zweizeitigen Vorgehens zunächst geschaffen werden. In dieser Zeit wird der Zahn über fünf Minuten in einer Tetrazyklinlösung gelagert, was bei offenem Foramen apicale die Wahrscheinlichkeit einer Pulpanekrose deutlich reduziert [Yanpiset et al. 2000]. Da die parodontale Prognose nach Kryopräservation und Transplantation mit einer einzeitigen Transplantation nahezu identisch ist [Kawasaki et al. 2004], erübrigt sich in den meisten Fällen die Verwendung weiterer antiresorptiver regenerationsfördernder Medikamente (Emdogain, (Straumann, Basel, oder Steroide) [Pohl et al. 2005]. Ausgenommen sind hiervon kryopräservierte avulsierte Zähne, die das gesamte Spektrum der heute üblichen medikamentösen Therapien enthalten [Andreasen 1992, Filippi 2008 a].
Bei wurzelunreifen Transplantaten, bei denen das Foramen apicale einen Durchmesser von 2 Millimetern (mm) nicht unter- und die Länge des Wurzelkanals eine Länge von 17 mm nicht überschritten hat, kann zunächst auf eine Wurzelkanalbehandlung verzichtet werden [Price & Cserepfalvi 1972, Andreasen et al. 1995]. Sollte es trotzdem nicht zu einer Revaskularisation kommen, schließt sich eine Wurzelkanalbehandlung im Sinne einer Apexifikation mit MTA (Dentsply, Maillefer, Ballaigues, CH) oder die heute üblichere Revitalisierung an. Dies setzt engmaschige klinische und radiologische Nachuntersuchungen voraus, damit das Ausbleiben einer Revaskularisation möglichst schnell erkannt werden kann. Bei wurzelreifen Zähnen ist keine Revaskularisation zu erwarten. Eine Wurzelkanalbehandlung während (retrograde Stiftinsertion) oder bald nach der Transplantation (konventionell) ist erforderlich. Für die sich der Transplantation anschließende Schienung hat sich die TTS-Schiene etabliert (Medartis, Basel, CH). Die Schienungsdauer beträgt nur wenige Wochen.
Regelmäßige klinische (Inspektion, Zahnbeweglichkeit, Periotest, Sondierungstiefen, Bleeding on probing, Sensibilität) und radiologische Kontrollen müssen in den ersten zwölf Monaten nach Transplantation erfolgen. Erst nach etwa einem Jahr kann auch die Revaskularisation der Pulpa sicher diagnostiziert werden. Die Risikofaktoren für einen Misserfolg (Pulpanekrose, infektionsbedingte Wurzelresorption, invasive zervikale Resorption, Ankylose) werden grundsätzlich nicht davon beeinflusst, ob die Transplantation einzeitig oder zweizeitig durchgeführt wurde [Filippi 2008 b].
Schlussfolgerung
Die primär jugendlichen Patienten profitieren mit der Möglichkeit einer Kryopräservation gegebenenfalls zu einem späteren Zeitpunkt vom Erhalt eines eigenen Zahnes, der aus Platzmangel (Prämolaren, Weisheitszähne) beziehungsweise durch Unfall oder Kieferfraktur entfernt wurde. Solange keine klinisch relevante Möglichkeit besteht, vitale Zähne im Labor zu züchten und Implantate kein vitales Parodont induzieren können und somit im noch wachsenden Kiefer nicht inseriert werden dürfen, wird der Stellenwert der autologen Zahntransplantation und der Kryopräservation bei Kindern und Jugendlichen stetig steigen.
Dr. med. dent. Melanie ZimmerliKlinik für zahnärztliche Chirurgie, -Radiologie, Mund- und Kieferheilkunde und ZahnunfallzentrumUniversitätskliniken für ZahnmedizinHebelstrasse 3CH- 4056 Baselmelanie.zimmerli@unibas.ch
Prof. Dr. med. dent. Andreas FilippiKlinik für zahnärztliche Chirurgie, -Radiologie, Mund- und Kieferheilkunde und ZahnunfallzentrumUniversitätskliniken für ZahnmedizinHebelstrasse 3CH- 4056 Baselandreas.filippi@unibas.chwww.andreas-filippi.ch
Dieser Beitrag ist modifiziert aus: SSO Schweizer Monatsschrift für Zahnmedizin 120, 423-428, (2010) und erscheint mit freundlicher Genehmigung des Verlags.